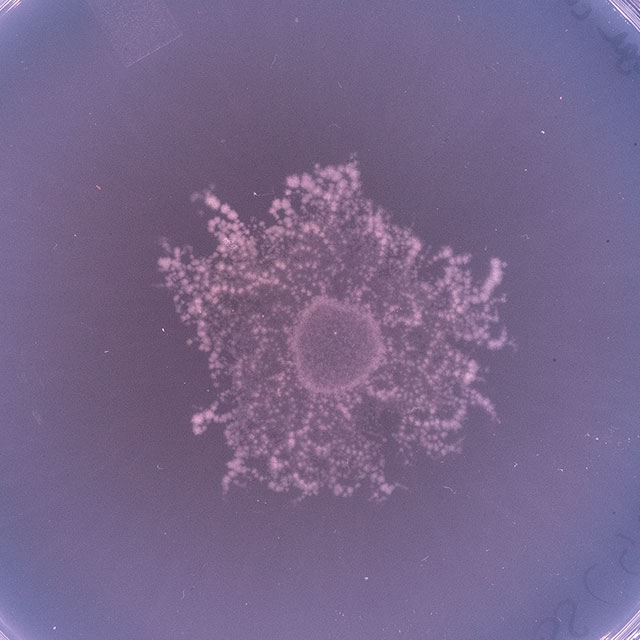
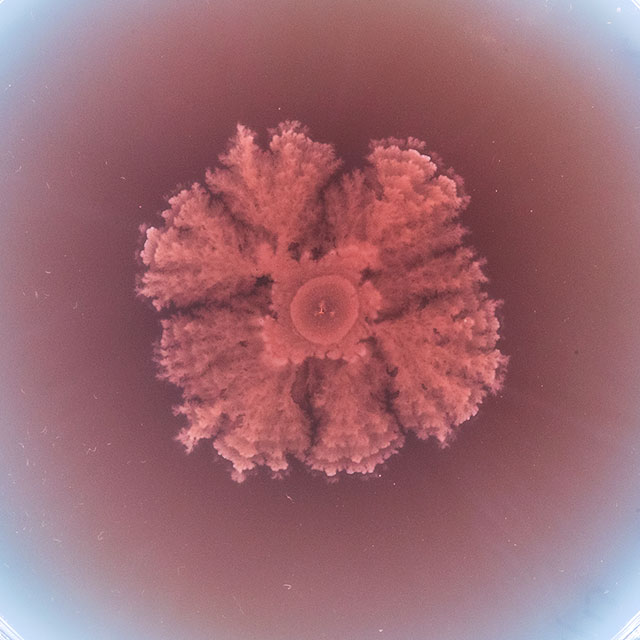
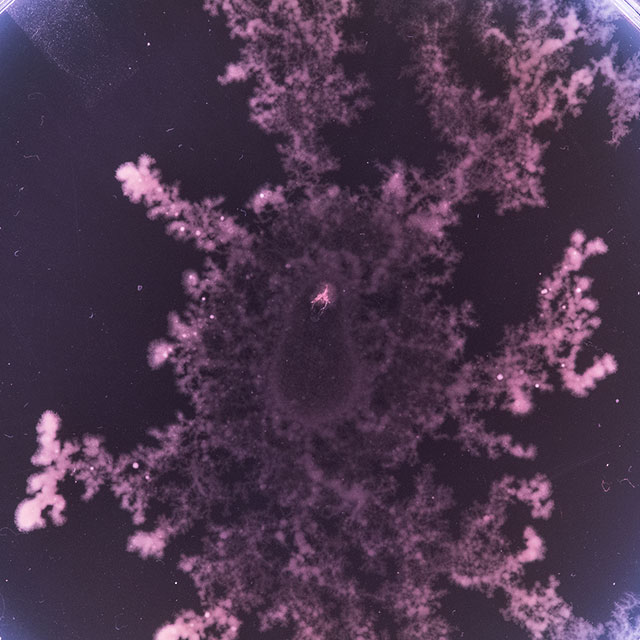
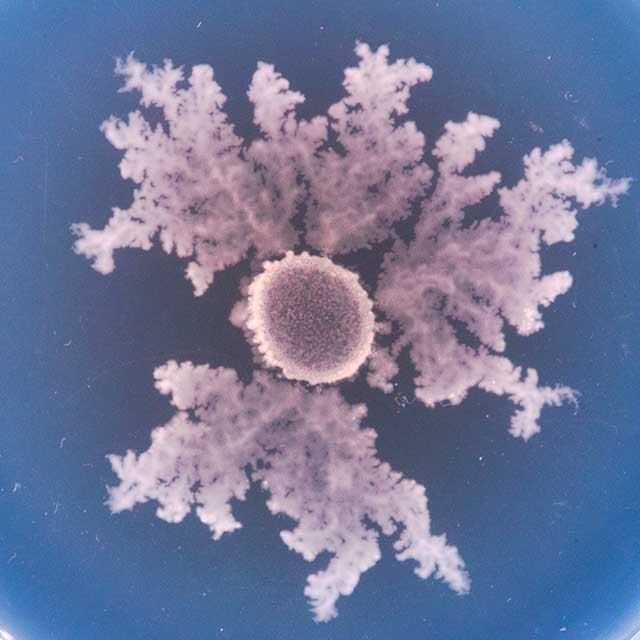
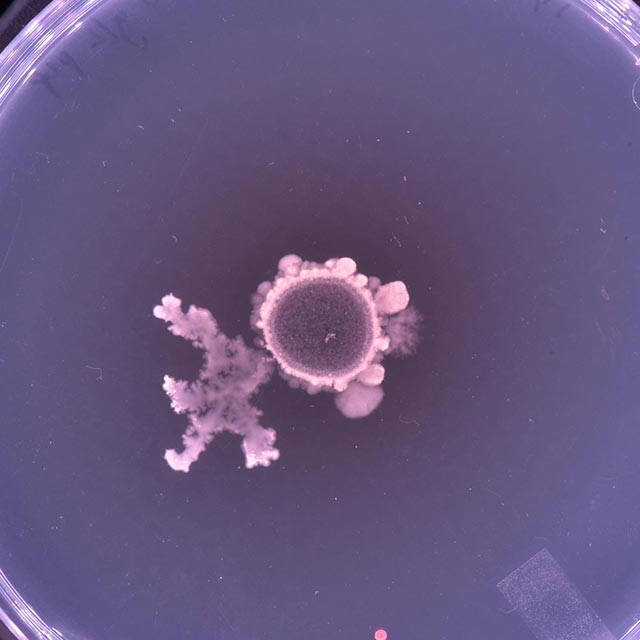

[phylum]
Bacteria cultures, robotic arm,
custom hardware, custom software
2020 - ongoing
A [phylum] project
Beauty is a hybrid machine-microbial artwork, currently in development by [phylum] (Carlos Castellanos, Johnny DiBlasi, Bello Bello), an experimental research collective specializing in cultural production informed by the intersections of science, technology and the arts. The work features a bio-driven artificial intelligence system that remediates a contaminated soil ecology while generating an audio-visual composition in real-time. It creates a situation where the fates of the contaminated soil and a group of bacterial cultures are determined by the whims of a artificial intelligence learning agent with an internal model of “beauty”. The agent builds its model by observing the cooperative pattern-forming behaviors of Paenibacillus sp and other bacteria that exhibit collective social motility, producing intricate, branching growth patterns in response to environmental conditions. The agent then attempts to spatially modify the bacterial growth by introducing chemical attractants and repellents. Images of bacterial colony growth and movement are captured using time-lapse photography and analyzed by the agent to determine how well the colonies conform to its internal model of beauty. The more beautiful the growth patterns of the bacteria appear to the agent the more of a remediating solution the soil receives and the more nutrients the bacterial cultures receive. It is known however, that these bacteria only produce their intricate patterns under environmental stressors such as lack of food and moisture. Thus, the agent also has to reduce nutrient levels and introduce stress-inducing chemicals (e.g. non-lethal concentrations of antibiotics) into the bacterial cultures in order to properly remediate the contaminated soil. In essence, the bacteria may have to starve themselves in order to look beautiful for the agent.

The agent in a sense is acting as a kind of sculptor or film director, shaping the colonies according to the vagaries of its aesthetic inclination. The agent will also express its “feelings” about this process via a series of evolving sound and visual patterns. It will attempt to ascertain the overall state of the colonies by clustering the growth patterns into groups which correspond to their beauty as well as their perceived health status. These groups will correspond to different sound and visual instruments that trigger in response to the agent’s analysis. The soil will be remediated with a solution containing several bacterial species known for their remediation potential. In addition to their pattern-forming characteristics, several Paenibacillus species are currently being researched for their ability to aid in the bioremediation of heavy metals and polycyclic aromatic hydrocarbons (e.g. motor oil, coal, etc) that are often found in soils, rivers, estuarine and coastal sediments. In addition, Pseudomonas putida is a well-known bioremediating bacterial species. The system will be setup to run indefinitely with an indeterminate outcome. Prints of the most beautiful bacterial patterns (as determined by the AI agent) will be displayed and sold to the public as mementos of the bacteria’s sacrifice and the AI’s aesthetic judgment.
Thematic Statement
Part of larger investigations into the potential of combining non-human and computational intelligence in the development of culturally evocative digital media systems, Beauty is defined by a confluence of themes: ecology, microbial and machine agency and cultural notions of beauty and aesthetics. Foregrounding processes of renewal and emergence via a systems-based approach, Beauty addresses timely and relevant issues by establishing a unique interplay between “primitive” microorganisms, the aforementioned notions of beauty and aesthetic judgement, the status and implications of intelligent machines and the impact of humans (and their technologies) on our ecology. In addition, while today all manner of microorganic labor is marshaled to produce products for humanity ranging (not to mention their use in cleaning up our environmental messes), we recognize these creatures as lively and dynamic, with agency and lifeworlds of their own. Thus the motivation for this work lies in creating an interface or window through which these organisms can convey their complexity and otherness using a language that can be understood by humans and the intelligent systems they create, and in doing so, subtly questioning anthropocentric ontologies and ways of knowing. Furthermore, as an artwork that engages critically and materially with computational, environmental and biological methods and technologies, this work transposes familiar categories and complicates the social demarcations between art and science. We hope that this “creative misuse” of biology and AI, will inspire new ways of looking at the relationship between humans, technology and the more than human world.